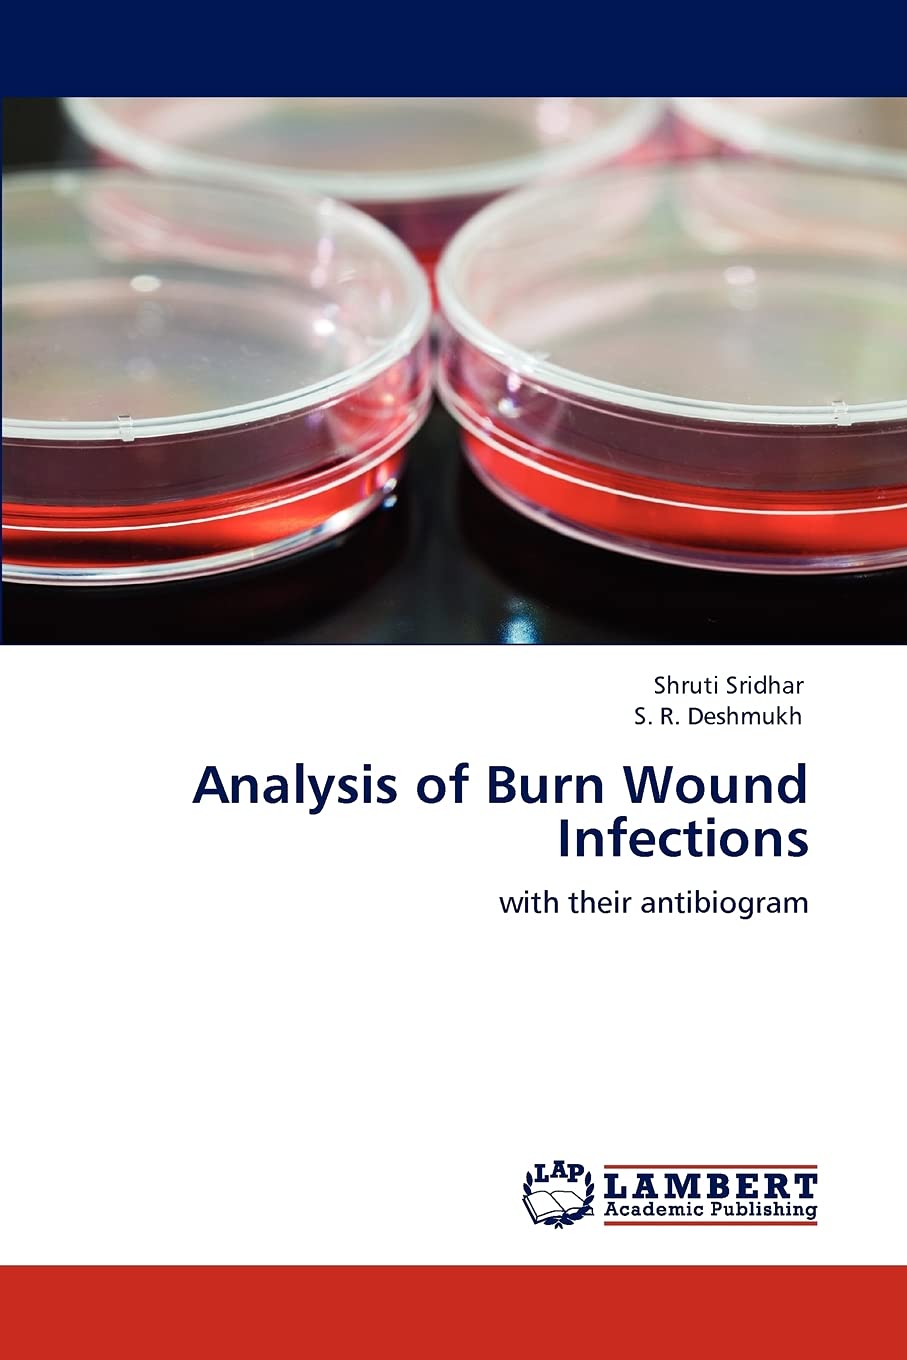

Title
Analysis of Burn Wound Infections: with their antibiogram,Used
Delivery time: 8-12 business days (International)
Burn wound Infection is the major cause of mortality in burn patients. The constant change in the resistance pattern of micro organisms make the treatment of such infections challenging and difficult. Understanding of the pathogenesis of burn wound infection is essential because the correct intervention can then be applied at the various stages. Antibiotics only act as an adjunct to the other procedures like disinfection of the wound, excision of the eschar, proper bandaging and topical applications. Also, since skin has a vast surface area, dehydration is a common occurrence and thus replenishment of fluids is also vital. Isolation of the ward and antisepsis are also very important to avoid nosocomial infections. Thus, multicentric studies and periodic survey, coupled with the judicious use of antibiotics is the key to this problem.
By changing our most important processes and
products, we have already made a big leap forward. This ranges from the
increased use of more sustainable fibers to the use of more
environmentally friendly printing processes to the development of
efficient waste management in our value chain.
Shipping & Returns
Shipping
We ship your order within 2–3 business days for USA deliveries and 5–8 business days for international shipments. Once your package has been dispatched from our warehouse, you'll receive an email confirmation with a tracking number, allowing you to track the status of your delivery.
Returns
To facilitate a smooth return process, a Return Authorization (RA) Number is required for all returns. Returns without a valid RA number will be declined and may incur additional fees. You can request an RA number within 15 days of the original delivery date. For more details, please refer to our Return & Refund Policy page.
Shipping & Returns
Shipping
We ship your order within 2–3 business days for USA deliveries and 5–8 business days for international shipments. Once your package has been dispatched from our warehouse, you'll receive an email confirmation with a tracking number, allowing you to track the status of your delivery.
Returns
To facilitate a smooth return process, a Return Authorization (RA) Number is required for all returns. Returns without a valid RA number will be declined and may incur additional fees. You can request an RA number within 15 days of the original delivery date. For more details, please refer to our Return & Refund Policy page.
Warranty
We provide a 2-year limited warranty, from the date of purchase for all our products.
If you believe you have received a defective product, or are experiencing any problems with your product, please contact us.
This warranty strictly does not cover damages that arose from negligence, misuse, wear and tear, or not in accordance with product instructions (dropping the product, etc.).
Warranty
We provide a 2-year limited warranty, from the date of purchase for all our products.
If you believe you have received a defective product, or are experiencing any problems with your product, please contact us.
This warranty strictly does not cover damages that arose from negligence, misuse, wear and tear, or not in accordance with product instructions (dropping the product, etc.).
Secure Payment
Your payment information is processed securely. We do not store credit card details nor have access to your credit card information.
We accept payments with :
Visa, MasterCard, American Express, Paypal, Shopify Payments, Shop Pay and more.
Secure Payment
Your payment information is processed securely. We do not store credit card details nor have access to your credit card information.
We accept payments with :
Visa, MasterCard, American Express, Paypal, Shopify Payments, Shop Pay and more.